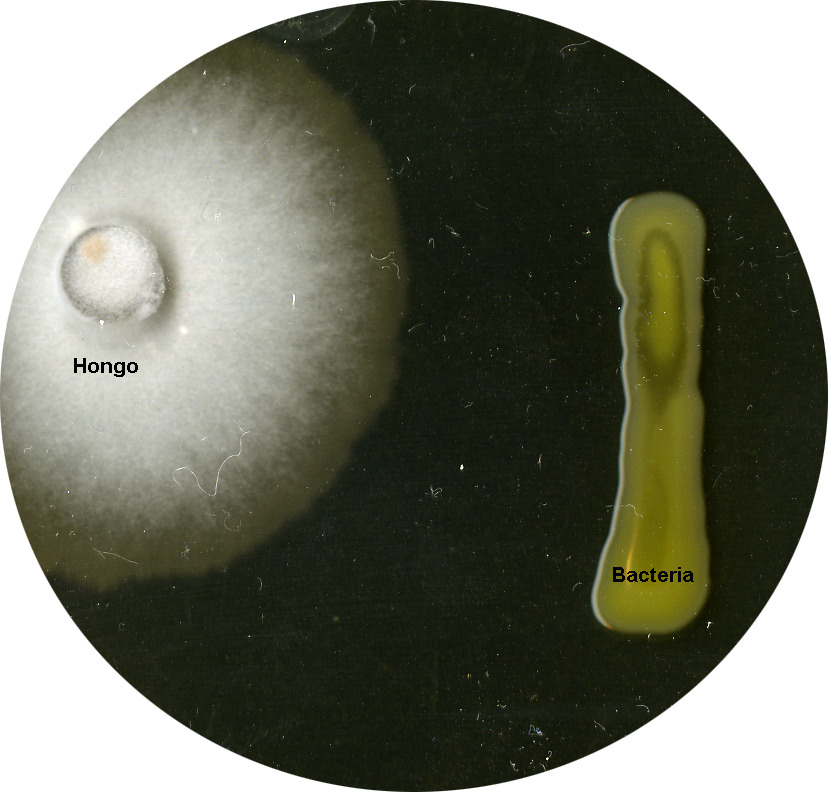

Ciencia y Suelo: Hallazgo de bacterias benéficas en La Araucanía promete cultivos más verdes
![]()
Se trata Microorganismos promotores del crecimiento vegetal que no habían sido descritos previamente y que permitirán una agricultura más sustentable
Tras dos años de investigación científica del Centro de Genómica Nutricional Agroacuícola (CGNA) se logró descubrir e identificar nuevas bacterias benéficas para las plantas, presentes en los suelos de La Araucanía. El hallazgo permitirá desarrollar insumos para una agricultura sustentable libre de compuestos químicos y con el potencial de enfrentar de mejor manera el cambio climático.
Estos resultados fueron encontrados en el marco del proyecto Fortalecimiento al Desarrollo Científico de Centros Regionales denominado “Señalización y respuesta de las leguminosas de grano al estrés ambiental”, financiado por la Agencia Nacional de Investigación y Desarrollo- ANID, en colaboración con los investigadores del Laboratorio de Ecología Microbiana Aplicada de la Universidad de la Frontera el Dr. Milko Jorquera y la Dra. Jacqueline Acuña.
Se trata del hallazgo de un grupo de bacterias promotoras del crecimiento en leguminosas de grano como el lupino y que también ha mostrado resultados satisfactorios en otras leguminosas y cereales como el trigo. De estas bacterias, cinco de ellas corresponden a nuevas especies.
La Dra. Grace Armijo, investigadora de leguminosas de grano del CGNA explicó que existen microorganismos buenos o beneficiosos en la naturaleza y muchos de ellos interactúan con las plantas. “Nosotros descubrimos algunas de estas bacterias asociadas a los nódulos de lupinos silvestres y logramos secuenciar su genoma completo. Esta información pronto estará disponible en bases de datos públicas”.
En este contexto, la Investigadora del CGNA agregó que “pudimos describir sus beneficios para las plantas, tales como aumentar su crecimiento en condiciones de estrés como la falta de agua, o la deficiencia de nutrientes como el fósforo o el nitrógeno, esenciales para el crecimiento, desarrollo y producción de proteína vegetal”.
“Muchas de estas bacterias que estudiamos tienen la capacidad de fijar el nitrógeno atmosférico, o solubilizar el fosfato de los suelos, de manera que los transforman en moléculas “biodisponibles” que pueden ser asimiladas por las plantas”, afirmó la Doctora Grace Armijo.
“También hemos identificado microorganismos biocontroladores de las principales enfermedades del lupino, como la antracnosis y la mancha café, ambas causadas por hongos”, explicó la investigadora del CGNA.
La Dra. Armijo agregó que para llegar a estos resultados fueron estudiados más de quinientos microorganismos de los suelos de La Araucanía, de las cuales al menos doscientos fueron analizados en el laboratorio para llegar a este primer grupo de bacterias benéficas.
“De aquí a fin de año estaremos en condiciones de presentar nuestros hallazgos a través de publicaciones científicas aportando al desarrollo de cultivos sustentables no solo para Chile, sino para otros países que también están en la carrera por una agricultura más natural”, indicó la científica del CGNA
En el escenario de cambio climático “se ha descubierto que estas bacterias no solamente pueden hacer crecer mejor a las plantas y las protegen de algunos patógenos oportunistas, sino que también pueden mejorar la tolerancia de las plantas ante estreses ambientales”, destacó el Doctor Milko Jorquera.
Aplicaciones
Cabe señalar que un 5% de las bacterias analizadas posee la capacidad de solubilizar fosfato orgánico e inorgánico, es decir, hacen que este fósforo esté disponible para la planta, por lo que podrían ser utilizadas como potenciales biofertilizantes fosfatados disminuyendo nuestra dependencia a este tipo de fertilizantes químicos.
Por otro lado, un 7% de las bacterias son fijadoras de nitrógeno, por lo que podrían ser utilizadas como biofertilizantes, disminuyendo el uso de compuestos nitrogenados que contaminan el ecosistema.
En consecuencia, estas bacterias podrían usarse en forma conjunta, para aprovechar al máximo sus beneficios con una sola aplicación de ellas en la semilla o en el campo.
“Es por ello que actualmente nos encontramos caracterizando los efectos de estas bacterias de manera combinada (consorcios) mediante ensayos en co-cultivo con plantas en condiciones de laboratorio y de invernadero, con la finalidad de obtener potenciales biofertilizantes y biopesticidas, para su aplicación lo más pronto posible”, aseguro la Dra. Armijo.
Importancia
En Chile, debido al origen de los suelos, su geografía diversa y características climáticas, el porcentaje de suelo cultivable es bajo, con sólo el 2.6% de la superficie total del país.
Los suelos cultivables enfrentan varios problemas que afectan la productividad agrícola y la sostenibilidad a largo plazo.
Específicamente en la región de La Araucanía, la acidez de los suelos debido a su origen, a la alta precipitación y la lixiviación de minerales básicos, puede afectar negativamente el crecimiento de los cultivos.
Se estima que aproximadamente el 70% de los suelos de La Araucanía son ácidos, con un pH menor a 5.5. Esta acidez es un factor limitante para la agricultura, ya que puede afectar la disponibilidad de nutrientes y la salud de los cultivos.
En muchos suelos de La Araucanía, el fósforo puede ser limitado debido a la acidez, tendiendo a formar compuestos de fósforo insolubles, lo que reduce la disponibilidad de este nutriente para las plantas.

